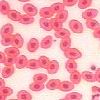
Twintig maal vergroting

Components of the microscope
- Microscope
- Microscope stand
- Base
- Power switch: On / off (front left)
- Light source
- Voltage control / rheostat (back right)
1 | 3 | 5 | 7 | 9 | 10 - Left and right focus adjustment knobs
- Condensor
- Iris diaphragm lever
Open | Closed - Condenser adjustment knob (left)
- Stage
- Stage controls (right beneath stage)
- Control for left and right (bottom)
- Control for forward and backward (top)


- Optical unit
- Nosepiece
- 4X objective (red ring)
- 10X objective (yellow ring)
- 40X objective (blue ring)
- 100X oil immersion objective (black and white rings)
- Binocular tube
- 10X eyepiece / ocular
- Interpupillary distance scale in mm (between oculars)
- Diopter adjustment ring (on left ocular)